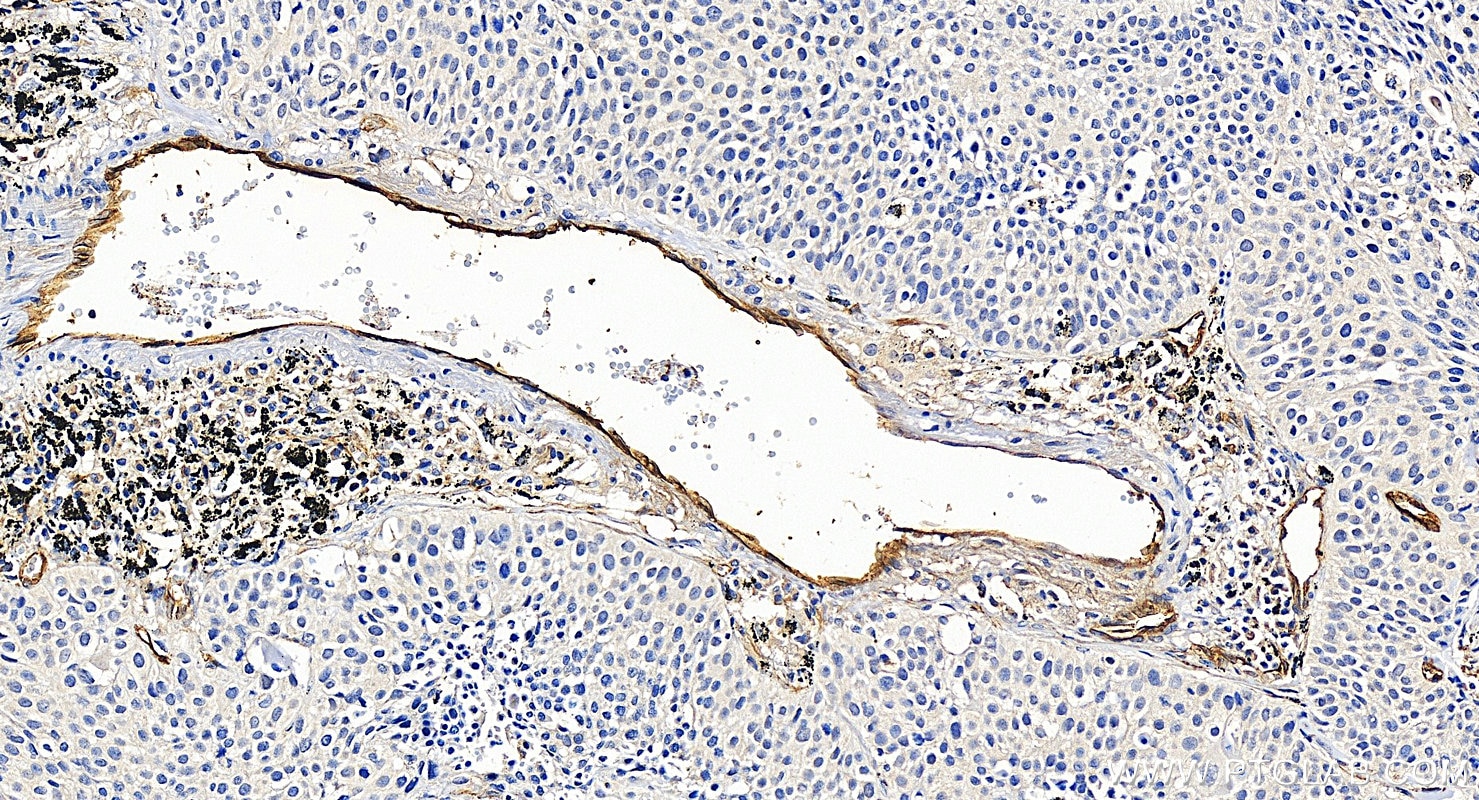
Immunohistochemical analysis of paraffin-embedded human lung cancer tissue slide using 10862-1-AP (Endoglin/CD105 antibody) at dilution of 1:4000 (under 20x lens). Heat mediated antigen retrieval with Tris-EDTA buffer (pH 9.0). Immunohistochemistry (IHC) staining of human lung cancer tissue using Endoglin/CD105 Polyclonal antibody (10862-1-AP)

Tested Applications
| Positive WB detected in | HUVEC cells, HeLa cells, human placenta tissue, mouse lung tissue, rat lung tissue |
| Positive IP detected in | mouse lung tissue |
| Positive IHC detected in | human breast cancer tissue, human liver cancer tissue, human lung cancer tissue, human placenta tissue, rat kidney tissue Note: suggested antigen retrieval with TE buffer pH 9.0; (*) Alternatively, antigen retrieval may be performed with citrate buffer pH 6.0 |
| Positive IF-P detected in | human placenta tissue |
Recommended dilution
| Application | Dilution |
|---|---|
| Western Blot (WB) | WB : 1:500-1:2000 |
| Immunoprecipitation (IP) | IP : 0.5-4.0 ug for 1.0-3.0 mg of total protein lysate |
| Immunohistochemistry (IHC) | IHC : 1:1000-1:4000 |
| Immunofluorescence (IF)-P | IF-P : 1:50-1:500 |
| It is recommended that this reagent should be titrated in each testing system to obtain optimal results. | |
| Sample-dependent, Check data in validation data gallery. | |
Published Applications
| KD/KO | See 2 publications below |
| WB | See 21 publications below |
| IHC | See 14 publications below |
| IF | See 20 publications below |
| IP | See 1 publications below |
Product Information
10862-1-AP targets Endoglin/CD105 in WB, IHC, IF-P, IP, ELISA applications and shows reactivity with human, mouse, rat samples.
| Tested Reactivity | human, mouse, rat |
| Cited Reactivity | human, mouse, rat, bovine |
| Host / Isotype | Rabbit / IgG |
| Class | Polyclonal |
| Type | Antibody |
| Immunogen |
CatNo: Ag1287 Product name: Recombinant human Endoglin/CD105 protein Source: e coli.-derived, PGEX-4T Tag: GST Domain: 331-658 aa of BC014271 Sequence: GGRLQTSPAPIQTTPPKDTCSPELLMSLIQTKCADDAMTLVLKKELVAHLKCTITGLTFWDPSCEAEDRGDKFVLRSAYSSCGMQVSASMISNEAVVNILSSSSPQRKKVHCLNMDSLSFQLGLYLSPHFLQASNTIEPGQQSFVQVRVSPSVSEFLLQLDSCHLDLGPEGGTVELIQGRAAKGNCVSLLSPSPEGDPRFSFLLHFYTVPIPKTGTLSCTVALRPKTGSQDQEVHRTVFMRLNIISPDLSGCTSKGLVLPAVLGITFGAFLIGALLTAALWYIYSHTRSPSKREPVVAVAAPASSESSSTNHSIGSTQSTPCSTSSMA Predict reactive species |
| Full Name | endoglin |
| Calculated Molecular Weight | 71 kDa |
| Observed Molecular Weight | 75-90 kDa, 170-180 kDa |
| GenBank Accession Number | BC014271 |
| Gene Symbol | CD105 |
| Gene ID (NCBI) | 2022 |
| RRID | AB_2098906 |
| Conjugate | Unconjugated |
| Form | Liquid |
| Purification Method | Antigen affinity purification |
| UNIPROT ID | P17813 |
| Storage Buffer | PBS with 0.02% sodium azide and 50% glycerol, pH 7.3. |
| Storage Conditions | Store at -20°C. Stable for one year after shipment. Aliquoting is unnecessary for -20oC storage. 20ul sizes contain 0.1% BSA. |
Background Information
Endoglin (ENG, CD105) is a homodimeric cell membrane glycoprotein of 180 kDa, composed of disulphide-linked subunits of 90-95 kDa. Endoglin is a proliferation-associated and hypoxia-inducible protein mainly expressed on vascular endothelial cells. It acts as an accessory receptor for transforming growth factor beta (TFG-β) and is involved in vascular development and remodelling. The important role of Endoglin in angiogenesis and in tumor progression makes it an ideal target for antiangiogenic therapy and a good marker for tumor prognosis. (PMID: 1326540; 14528280; 21737653; 12773481)
Protocols
| Product Specific Protocols | |
|---|---|
| IF protocol for Endoglin/CD105 antibody 10862-1-AP | Download protocol |
| IHC protocol for Endoglin/CD105 antibody 10862-1-AP | Download protocol |
| IP protocol for Endoglin/CD105 antibody 10862-1-AP | Download protocol |
| WB protocol for Endoglin/CD105 antibody 10862-1-AP | Download protocol |
| Standard Protocols | |
|---|---|
| Click here to view our Standard Protocols |
Publications
| Species | Application | Title |
|---|---|---|
Nat Commun Injectable ECM-mimetic dynamic hydrogels abolish ferroptosis-induced post-discectomy herniation through delivering nucleus pulposus progenitor cell-derived exosomes | ||
Dev Cell Endothelial progenitor cells control remodeling of uterine spiral arteries for the establishment of utero-placental circulation | ||
Stem Cell Res Ther Controlled release of hydrogel-encapsulated mesenchymal stem cells-conditioned medium promotes functional liver regeneration after hepatectomy in metabolic dysfunction-associated steatotic liver disease | ||
Cancers (Basel) WISP2/CCN5 Suppresses Vasculogenic Mimicry through Inhibition of YAP/TAZ Signaling in Breast Cancer Cells. | ||
Int J Biol Sci Roquin2 suppresses breast cancer progression by inhibiting tumor angiogenesis via selectively destabilizing proangiogenic factors mRNA. | ||
Biomedicines Endoglin Modulates TGFβR2 Induced VEGF and Proinflammatory Cytokine Axis Mediated Angiogenesis in Prolonged DEHP-Exposed Breast Cancer Cells.
|
Reviews
The reviews below have been submitted by verified Proteintech customers who received an incentive for providing their feedback.
FH Sai Sindhura (Verified Customer) (01-08-2026) | Endoglin/CD105 antibody works very well
|